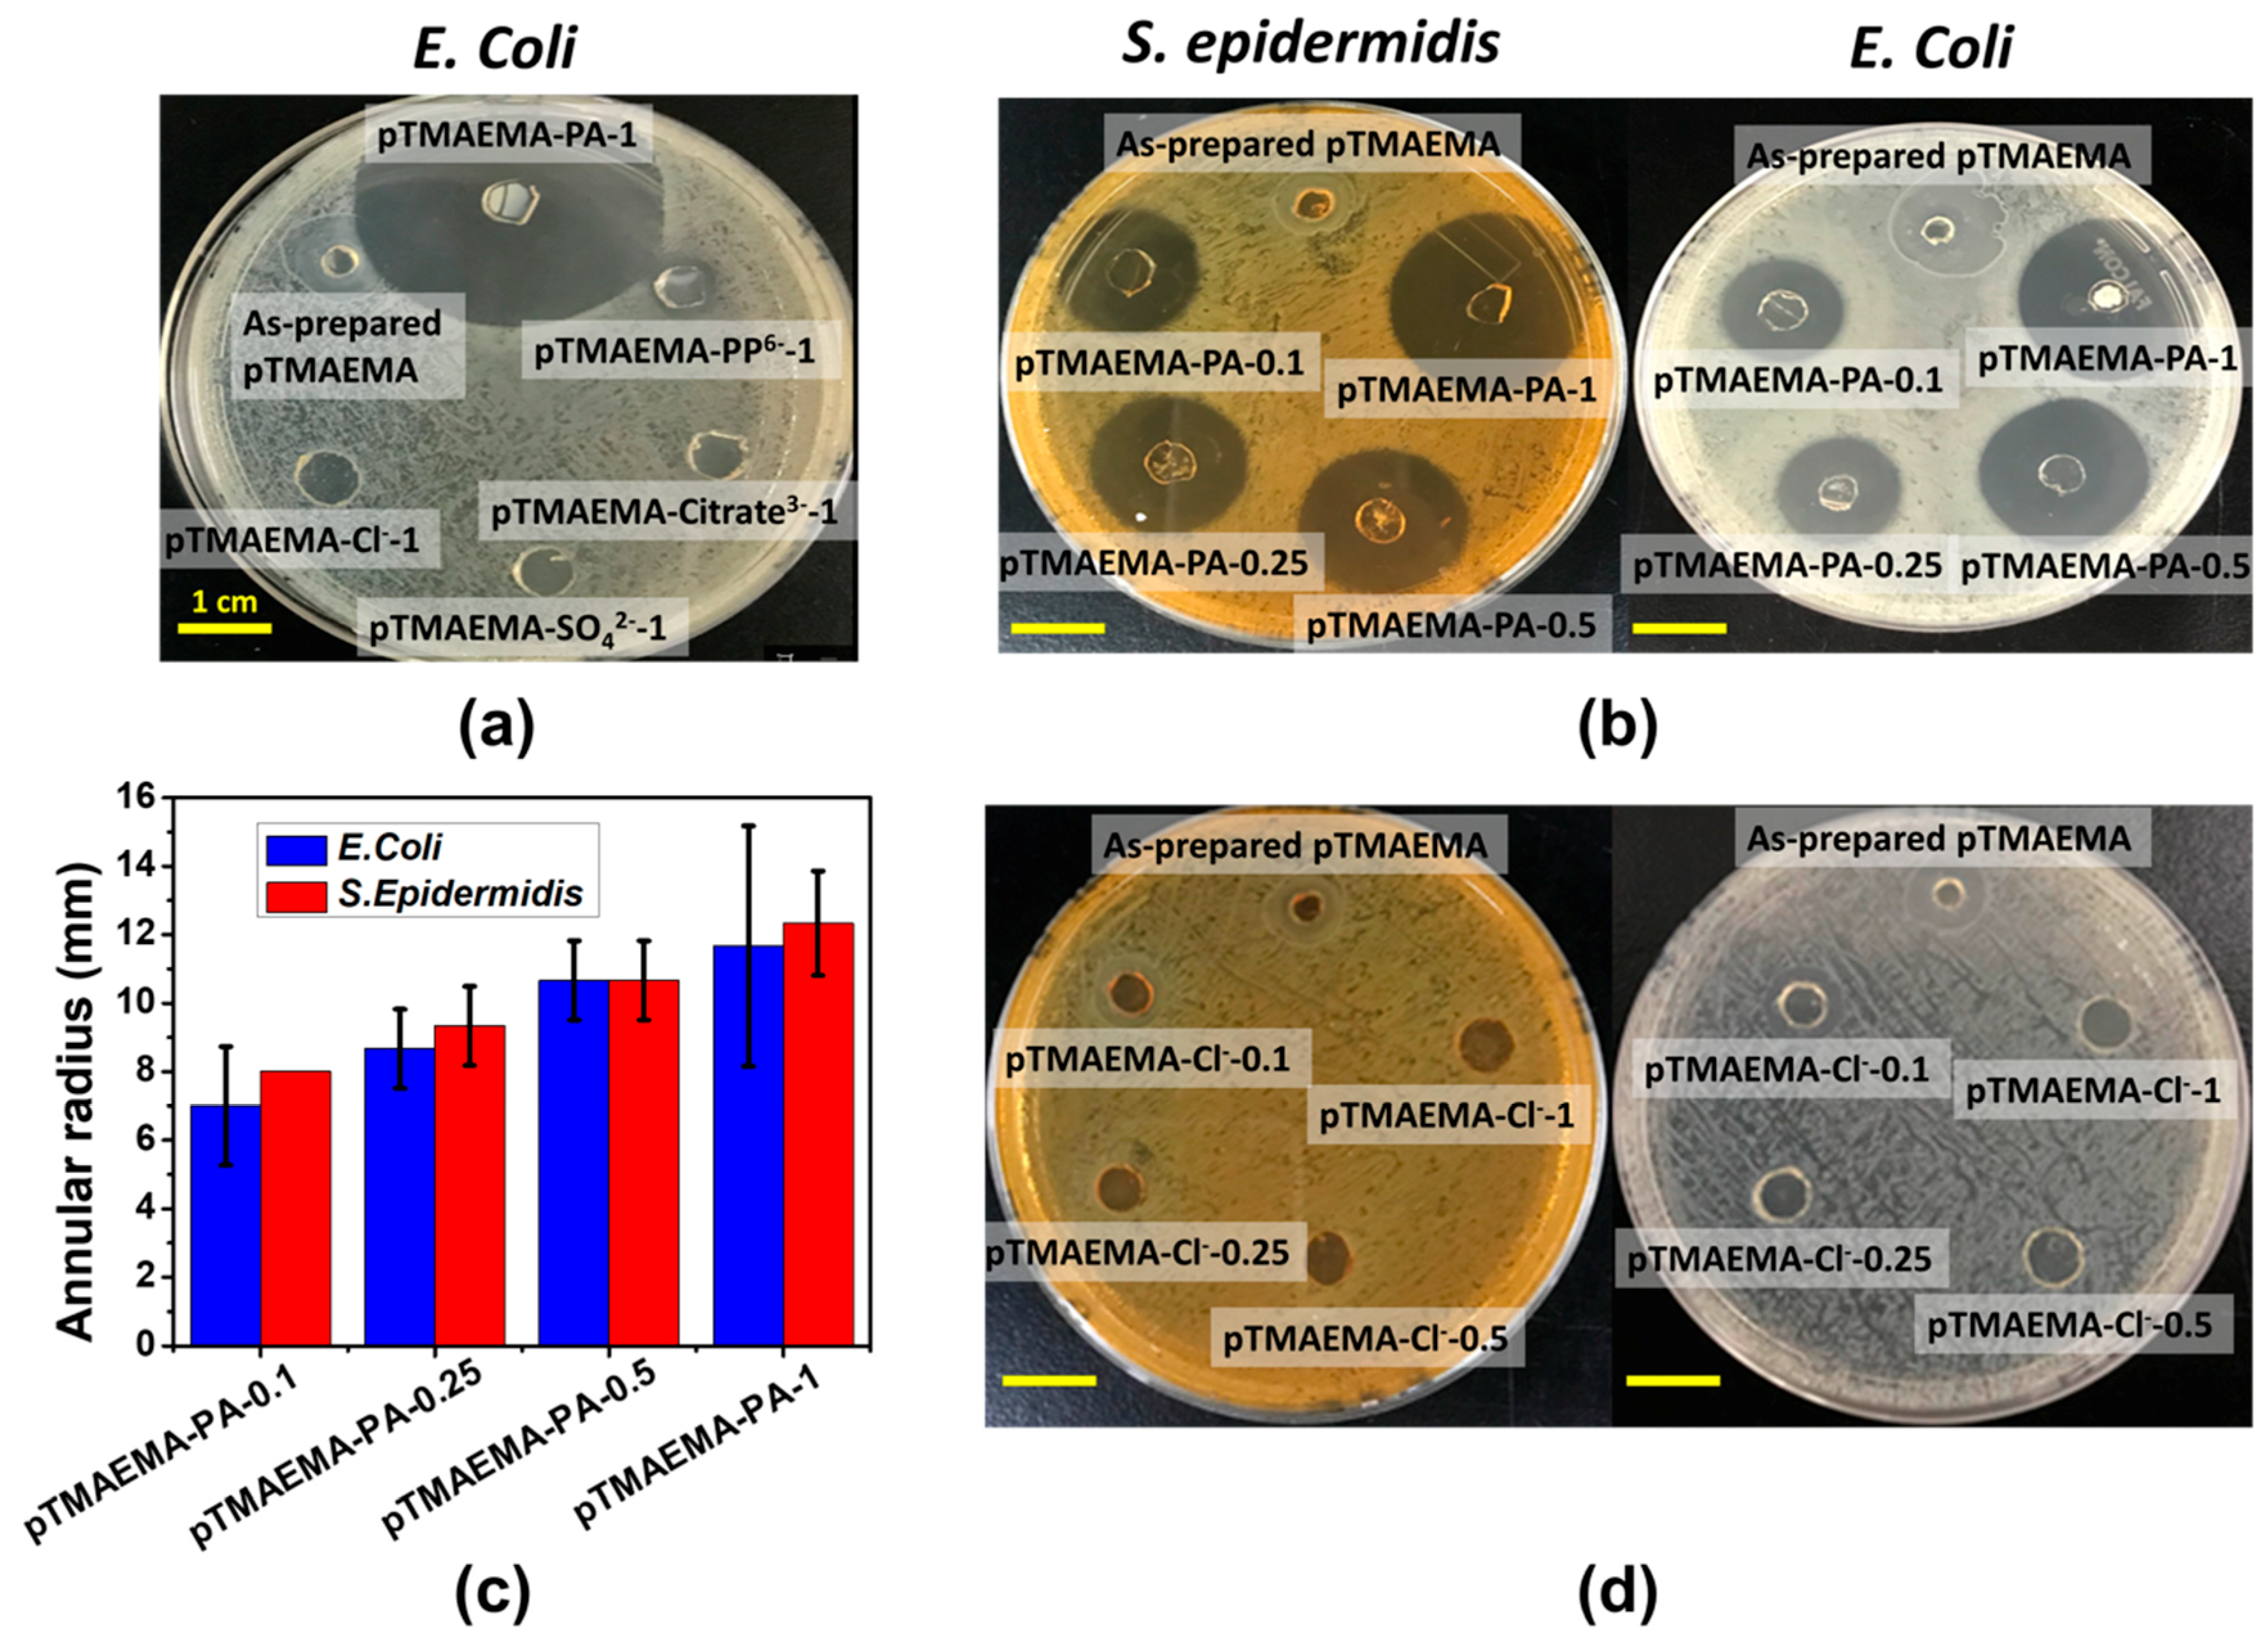
Polymers 11 01721 g009 Polymers 11 01721 g009

Tough Polyelectrolyte Hydrogels with Antimicrobial Property via Incorporation of Natural Multivalent Phytic Acid
Abstract
1. Introduction
2. Materials and Methods
2.1. Materials
2.2. Preparation of Polycationic Hydrogels
2.3. Compressive Mechanical Test
2.4. Rheological Test
2.5. Stability Test
2.6. Swelling Ratio Measurement
2.7. Fourier Transformed Infrared (FTIR) Spectra Analysis of pTMAEMA, PA and pTMAEMA-PA Hydrogels
2.8. Bacterial Attachment Test
2.9. Antibacterial Activity
3. Results and Discussion
3.1. The Effect of Loading Concentration of PA on Mechanical Properties of pTMAEMA
3.2. The Fatigue-Resistant Properties and Self-Recovery of pTMAEMA-PA
3.3. Counterion Exchange in pTMAEMA-PA
3.4. Counterion Effects on the Swelling Ratio and Mechanical Properties of Polyelectrolyte Hydrogels
3.5. FTIR Analysis
3.6. Bacterial Attachment Test of pTMAEMA-Counterions
3.7. Antibacterial Capability of pTMAEMA-PA
4. Conclusions
Supplementary Materials
Author Contributions
Funding
Conflicts of Interest
References
- Liu, Y.; He, W.; Zhang, Z.; Lee, B. Recent developments in tough hydrogels for biomedical applications. Gels 2018, 4, 46. [Google Scholar] [CrossRef] [PubMed]
- Liu, M.; Zeng, X.; Ma, C.; Yi, H.; Ali, Z.; Mou, X.; Li, S.; Deng, Y.; He, N. Injectable hydrogels for cartilage and bone tissue engineering. Bone res. 2017, 5, 17014. [Google Scholar] [CrossRef] [PubMed]
- Yuk, H.; Zhang, T.; Parada, G.A.; Liu, X.; Zhao, X. Skin-inspired hydrogel–elastomer hybrids with robust interfaces and functional microstructures. Nat. Commun. 2016, 7, 12028. [Google Scholar] [CrossRef] [PubMed]
- Liu, Z.; Calvert, P. Multilayer hydrogels as muscle-like actuators. Adv. Mater. 2000, 12, 288–291. [Google Scholar] [CrossRef]
- Gong, J.P. Why are double network hydrogels so tough? Soft Matter 2010, 6, 2583. [Google Scholar] [CrossRef]
- Haraguchi, K.; Takehisa, T. Nanocomposite hydrogels: a unique organic–inorganic network structure with extraordinary mechanical, optical, and swelling/de-swelling properties. Adv. Mater. 2002, 14, 1120–1124. [Google Scholar] [CrossRef]
- Chen, Q.; Zhu, L.; Chen, H.; Yan, H.; Huang, L.; Yang, J.; Zheng, J. A Novel Design Strategy for Fully Physically Linked Double Network Hydrogels with Tough, Fatigue Resistant, and Self-Healing Properties. Adv. Funct. Mater. 2015, 25, 1598–1607. [Google Scholar] [CrossRef]
- Zheng, S.Y.; Ding, H.; Qian, J.; Yin, J.; Wu, Z.L.; Song, Y.; Zheng, Q. Metal-Coordination Complexes Mediated Physical Hydrogels with High Toughness, Stick–Slip Tearing Behavior, and Good Processability. Macromolecules 2016, 49, 9637–9646. [Google Scholar] [CrossRef]
- Tang, L.; Liu, W.; Liu, G. High-strength hydrogels with integrated functions of H-bonding and thermoresponsive surface-mediated reverse transfection and cell detachment. Adv. Mater. 2010, 22, 2652–2656. [Google Scholar] [CrossRef]
- Mihajlovic, M.; Staropoli, M.; Appavou, M.-S.; Wyss, H.M.; Pyckhout-Hintzen, W.; Sijbesma, R.P. Tough supramolecular hydrogel based on strong hydrophobic interactions in a multiblock segmented copolymer. Macromolecules 2017, 50, 3333–3346. [Google Scholar] [CrossRef]
- Sun, T.L.; Kurokawa, T.; Kuroda, S.; Ihsan, A.B.; Akasaki, T.; Sato, K.; Haque, M.A.; Nakajima, T.; Gong, J.P. Physical hydrogels composed of polyampholytes demonstrate high toughness and viscoelasticity. Nat. Mater. 2013, 12, 932–937. [Google Scholar] [CrossRef] [PubMed]
- Allen, H.K.; Donato, J.; Wang, H.H.; Cloud-Hansen, K.A.; Davies, J.; Handelsman, J. Call of the wild: antibiotic resistance genes in natural environments. Nat. Rev. Microbiol. 2010, 8, 251. [Google Scholar] [CrossRef] [PubMed]
- Varaprasad, K.; Mohan, Y.M.; Ravindra, S.; Reddy, N.N.; Vimala, K.; Monika, K.; Sreedhar, B.; Raju, K.M. Hydrogel–silver nanoparticle composites: a new generation of antimicrobials. J. Appl. Polym. Sci. 2010, 115, 1199–1207. [Google Scholar] [CrossRef]
- Thoniyot, P.; Tan, M.J.; Karim, A.A.; Young, D.J.; Loh, X.J. Nanoparticle–hydrogel composites: Concept, design, and applications of these promising, multi-functional materials. Adv. Sci. 2015, 2, 1400010. [Google Scholar] [CrossRef]
- Ikeda, T.; Hirayama, H.; Yamaguchi, H.; Tazuke, S.; Watanabe, M. Polycationic biocides with pendant active groups: molecular weight dependence of antibacterial activity. Antimicrob. Agents Chemother. 1986, 30, 132–136. [Google Scholar] [CrossRef]
- Li, P.; Poon, Y.F.; Li, W.; Zhu, H.-Y.; Yeap, S.H.; Cao, Y.; Qi, X.; Zhou, C.; Lamrani, M.; Beuerman, R.W. A polycationic antimicrobial and biocompatible hydrogel with microbe membrane suctioning ability. Nat. Mater. 2011, 10, 149. [Google Scholar] [CrossRef]
- Eren, T.; Som, A.; Rennie, J.R.; Nelson, C.F.; Urgina, Y.; Nüsslein, K.; Coughlin, E.B.; Tew, G.N. Antibacterial and hemolytic activities of quaternary pyridinium functionalized polynorbornenes. Macromol. Chem. Phys. 2008, 209, 516–524. [Google Scholar] [CrossRef]
- Wang, J.; Chen, Y.P.; Yao, K.; Wilbon, P.A.; Zhang, W.; Ren, L.; Zhou, J.; Nagarkatti, M.; Wang, C.; Chu, F. Robust antimicrobial compounds and polymers derived from natural resin acids. Chem. Commun. 2012, 48, 916–918. [Google Scholar] [CrossRef]
- Gan, D.; Xu, T.; Xing, W.; Ge, X.; Fang, L.; Wang, K.; Ren, F.; Lu, X. Mussel-Inspired Contact-Active Antibacterial Hydrogel with High Cell Affinity, Toughness, and Recoverability. Adv. Funct. Mater. 2019, 29, 1805964. [Google Scholar] [CrossRef]
- Cheng, G.; Xue, H.; Zhang, Z.; Chen, S.; Jiang, S. A switchable biocompatible polymer surface with self-sterilizing and nonfouling capabilities. Angew. Chem. Int. Ed. 2008, 47, 8831–8834. [Google Scholar] [CrossRef]
- Huang, K.-T.; Fang, Y.-L.; Hsieh, P.-S.; Li, C.-C.; Dai, N.-T.; Huang, C.-J. Zwitterionic nanocomposite hydrogels as effective wound dressings. J. Mater. Chem. B 2016, 4, 4206–4215. [Google Scholar] [CrossRef]
- Zheng, H.-T.; Bui, H.L.; Chakroborty, S.; Wang, Y.; Huang, C.-J. PEGylated metal-phenolic networks for antimicrobial and antifouling properties. Langmuir 2019, 35, 8829–8839. [Google Scholar] [CrossRef] [PubMed]
- Wei, T.; Tang, Z.; Yu, Q.; Chen, H. Smart antibacterial surfaces with switchable bacteria-killing and bacteria-releasing capabilities. ACS Appl. Mater. Interfaces 2017, 9, 37511–37523. [Google Scholar] [CrossRef]
- Yu, Q.; Shivapooja, P.; Johnson, L.M.; Tizazu, G.; Leggett, G.J.; López, G.P. Nanopatterned polymer brushes as switchable bioactive interfaces. Nanoscale 2013, 5, 3632–3637. [Google Scholar] [CrossRef] [PubMed]
- Yan, S.; Shi, H.; Song, L.; Wang, X.; Liu, L.; Luan, S.; Yang, Y.; Yin, J. Nonleaching bacteria-responsive antibacterial surface based on a unique hierarchical architecture. ACS Appl. Mater. Interfaces 2016, 8, 24471–24481. [Google Scholar] [CrossRef] [PubMed]
- Wei, T.; Zhan, W.; Yu, Q.; Chen, H. Smart Biointerface with Photoswitched Functions between Bactericidal Activity and Bacteria-Releasing Ability. ACS Appl. Mater. Interfaces 2017, 9, 25767–25774. [Google Scholar] [CrossRef]
- Huang, C.-J.; Chen, Y.-S.; Chang, Y. Counterion-activated nanoactuator: reversibly switchable killing/releasing bacteria on polycation brushes. ACS Appl. Mater. Interfaces 2015, 7, 2415–2423. [Google Scholar] [CrossRef]
- Cowan, M.M. Plant products as antimicrobial agents. Clin. Microbiol. Rev. 1999, 12, 564–582. [Google Scholar] [CrossRef]
- Seeram, N.P.; Adams, L.S.; Henning, S.M.; Niu, Y.; Zhang, Y.; Nair, M.G.; Heber, D. In vitro antiproliferative, apoptotic and antioxidant activities of punicalagin, ellagic acid and a total pomegranate tannin extract are enhanced in combination with other polyphenols as found in pomegranate juice. J. Nutr. Biochem. 2005, 16, 360–367. [Google Scholar] [CrossRef]
- Gryglewski, R.J.; Korbut, R.; Robak, J.; Świȩs, J. On the mechanism of antithrombotic action of flavonoids. Biochem. Pharmacol. 1987, 36, 317–322. [Google Scholar] [CrossRef]
- Souza, S.; Aquino, L.; Milach, A.C., Jr.; Bandeira, M.; Nobre, M.; Viana, G. Antiinflammatory and antiulcer properties of tannins from Myracrodruon urundeuva Allemão (Anacardiaceae) in rodents. Phytother. Res. 2007, 21, 220–225. [Google Scholar] [CrossRef] [PubMed]
- Li, M.; Wang, H.; Hu, J.; Hu, J.; Zhang, S.; Yang, Z.; Li, Y.; Cheng, Y. Smart Hydrogels with Antibacterial Properties Built from All Natural Building Blocks. Chem. Mater. 2019, 31, 7678–7685. [Google Scholar] [CrossRef]
- Meininger, S.; Blum, C.; Schamel, M.; Barralet, J.E.; Ignatius, A.; Gbureck, U. Phytic acid as alternative setting retarder enhanced biological performance of dicalcium phosphate cement in vitro. Sci. Rep. 2017, 7, 558. [Google Scholar] [CrossRef] [PubMed]
- Chen, K.; Zhang, S.; Li, A.; Tang, X.; Li, L.; Guo, L. Bioinspired Interfacial Chelating-like Reinforcement Strategy toward Mechanically Enhanced Lamellar Materials. ACS nano 2018, 12, 4269–4279. [Google Scholar] [CrossRef]
- Barahuie, F.; Dorniani, D.; Saifullah, B.; Gothai, S.; Hussein, M.Z.; Pandurangan, A.K.; Arulselvan, P.; Norhaizan, M.E. Sustained release of anticancer agent phytic acid from its chitosan-coated magnetic nanoparticles for drug-delivery system. Int. J. Nanomedicine 2017, 12, 2361. [Google Scholar] [CrossRef]
- Patil, P.; Chavanke, D.; Wagh, M. A review on ionotropic gelation method: novel approach for controlled gastroretentive gelispheres. Int. J. Pharm. Pharm. Sci. 2012, 4, 27–32. [Google Scholar]
- Yang, C.H.; Wang, M.X.; Haider, H.; Yang, J.H.; Sun, J.-Y.; Chen, Y.M.; Zhou, J.; Suo, Z. Strengthening alginate/polyacrylamide hydrogels using various multivalent cations. ACS Appl. Mater. Interfaces 2013, 5, 10418–10422. [Google Scholar] [CrossRef]
- Azzaroni, O.; Zheng, Z.; Yang, Z.; Huck, W.T. Polyelectrolyte brushes as efficient ultrathin platforms for site-selective copper electroless deposition. Langmuir 2006, 22, 6730–6733. [Google Scholar] [CrossRef]
- Moya, S.; Azzaroni, O.; Farhan, T.; Osborne, V.L.; Huck, W.T. Locking and unlocking of polyelectrolyte brushes: toward the fabrication of chemically controlled nanoactuators. Angew. Chem. Int. Ed. Engl. 2005, 44, 4578–4581. [Google Scholar] [CrossRef]
- Azzaroni, O.; Brown, A.A.; Huck, W.T. Tunable wettability by clicking counterions into polyelectrolyte brushes. Adv. Mater. 2007, 19, 151–154. [Google Scholar] [CrossRef]
- Azzaroni, O.; Moya, S.; Farhan, T.; Brown, A.A.; Huck, W.T.S. Switching the Properties of Polyelectrolyte Brushes via “Hydrophobic Collapse”. Macromolecules 2005, 38, 10192–10199. [Google Scholar] [CrossRef]
- Liu, G. Tuning the Properties of Charged Polymers at the Solid/Liquid Interface with Ions. Langmuir 2018, 35, 3232–3247. [Google Scholar] [CrossRef] [PubMed]
- Debye, P. The theory of electrolytes I. The lowering of the freezing point and related occurrences. Phys. Z 1923, 24, 185–206. [Google Scholar]
- Kunz, W. Specific ion effects in colloidal and biological systems. Curr. Opin. Colloid Interface Sci. 2010, 15, 34–39. [Google Scholar] [CrossRef]
- Zhang, T.; Yan, H.; Shen, L.; Fang, Z.; Zhang, X.; Wang, J.; Zhang, B. Chitosan/phytic acid polyelectrolyte complex: a green and renewable intumescent flame retardant system for ethylene–vinyl acetate copolymer. Ind. Eng. Chem. Res. 2014, 53, 19199–19207. [Google Scholar] [CrossRef]
- Chen, P.-Y.; Courchesne, N.-M.D.; Hyder, M.N.; Qi, J.; Belcher, A.M.; Hammond, P.T. Carbon nanotube–polyaniline core–shell nanostructured hydrogel for electrochemical energy storage. RSC Adv. 2015, 5, 37970–37977. [Google Scholar] [CrossRef]
- Pan, L.; Yu, G.; Zhai, D.; Lee, H.R.; Zhao, W.; Liu, N.; Wang, H.; Tee, B.C.-K.; Shi, Y.; Cui, Y. Hierarchical nanostructured conducting polymer hydrogel with high electrochemical activity. Proc. Natl. Acad. Sci. USA 2012, 109, 9287–9292. [Google Scholar] [CrossRef]
- Pu, Q.; Ng, S.; Mok, V.; Chen, S.B. Ion bridging effects on the electroviscosity of flexible polyelectrolytes. J. Phys. Chem. B 2004, 108, 14124–14129. [Google Scholar] [CrossRef]
- Song, D.; Kang, B.; Zhao, Z.; Song, S. Stretchable self-healing hydrogels capable of heavy metal ion scavenging. RSC Adv. 2019, 9, 19039–19047. [Google Scholar] [CrossRef]
- Wang, C.; Deitrick, K.; Seo, J.; Cheng, Z.; Zacharia, N.S.; Weiss, R.; Vogt, B.D. Manipulating the mechanical response of hydrophobically cross-linked hydrogels with ionic associations. Macromolecules 2019, 52, 6055–6067. [Google Scholar] [CrossRef]
- Wang, T.; Long, Y.; Liu, L.; Wang, X.; Craig, V.S.; Zhang, G.; Liu, G. Cation-specific conformational behavior of polyelectrolyte brushes: from aqueous to nonaqueous solvent. Langmuir 2014, 30, 12850–12859. [Google Scholar] [CrossRef] [PubMed]
- Grosberg, A.Y.; Nguyen, T.; Shklovskii, B. Colloquium: the physics of charge inversion in chemical and biological systems. Rev. Mod. Phys. 2002, 74, 329. [Google Scholar] [CrossRef]
- Sing, C.E.; Zwanikken, J.W.; Olvera de la Cruz, M. Effect of ion–ion correlations on polyelectrolyte gel collapse and reentrant swelling. Macromolecules 2013, 46, 5053–5065. [Google Scholar] [CrossRef]
- Henderson, K.J.; Zhou, T.C.; Otim, K.J.; Shull, K.R. Ionically cross-linked triblock copolymer hydrogels with high strength. Macromolecules 2010, 43, 6193–6201. [Google Scholar] [CrossRef]
- Horkay, F.; Tasaki, I.; Basser, P.J. Osmotic swelling of polyacrylate hydrogels in physiological salt solutions. Biomacromolecules 2000, 1, 84–90. [Google Scholar] [CrossRef]
- de La Cruz, M.O.; Belloni, L.; Delsanti, M.; Dalbiez, J.; Spalla, O.; Drifford, M. Precipitation of highly charged polyelectrolyte solutions in the presence of multivalent salts. J. Chem. Phys. 1995, 103, 5781–5791. [Google Scholar] [CrossRef]
- Zhang, Y.; Furyk, S.; Bergbreiter, D.E.; Cremer, P.S. Specific ion effects on the water solubility of macromolecules: PNIPAM and the Hofmeister series. J. Am. Chem. Soc. 2005, 127, 14505–14510. [Google Scholar] [CrossRef]
- Nihonyanagi, S.; Yamaguchi, S.; Tahara, T. Counterion effect on interfacial water at charged interfaces and its relevance to the Hofmeister series. J. Am. Chem. Soc. 2014, 136, 6155–6158. [Google Scholar] [CrossRef]
- Wang, X.; Wen, K.; Yang, X.; Li, L.; Yu, X. Biocompatibility and anti-calcification of a biological artery immobilized with naturally-occurring phytic acid as the crosslinking agent. J. Mater. Chem. B 2017, 5, 8115–8124. [Google Scholar] [CrossRef]
- Kim, N.H.; Rhee, M.S. Phytic Acid and Sodium Chloride Show Marked Synergistic Bactericidal Effects against Nonadapted and Acid-Adapted Escherichia coli O157:H7 Strains. Appl. Environ. Microbiol. 2016, 82, 1040–1049. [Google Scholar] [CrossRef]
- Kim, N.H.; Rhee, M.S. Synergistic bactericidal action of phytic acid and sodium chloride against Escherichia coli O157: H7 cells protected by a biofilm. Int. J. Food Microbiol. 2016, 227, 17–21. [Google Scholar] [CrossRef] [PubMed]
- Percival, S.L.; Kite, P.; Eastwood, K.; Murga, R.; Carr, J.; Arduino, M.J.; Donlan, R.M. Tetrasodium EDTA as a novel central venous catheter lock solution against biofilm. Infect. Control Hosp. Epidemiol. 2005, 26, 515–519. [Google Scholar] [CrossRef] [PubMed]
- Gaetke, L.M.; McClain, C.J.; Toleman, C.J.; Stuart, M.A. Yogurt protects against growth retardation in weanling rats fed diets high in phytic acid. J. Nutr. Biochem. 2010, 21, 147–152. [Google Scholar] [CrossRef] [PubMed]
- Hiasa, Y.; Kitahori, Y.; Morimoto, J.; Konishi, N.; Nakaoka, S.; Nishioka, H. Carcinogenicity study in rats of phytic acid ‘Daiichi’, a natural food additive. Food Chem. Toxicol. 1992, 30, 117–125. [Google Scholar] [CrossRef]
- Szkudelski, T. Phytic acid–induced metabolic changes in the rat. J. Anim. Physiol. Anim. Nutr. 2005, 89, 397–402. [Google Scholar] [CrossRef] [PubMed]
- GRAS Notices. Available online: https://www.accessdata.fda.gov/scripts/fdcc/?set=GRASNotices&id=381 (accessed on 13 October 2019).

© 2019 by the authors. Licensee MDPI, Basel, Switzerland. This article is an open access article distributed under the terms and conditions of the Creative Commons Attribution (CC BY) license (http://creativecommons.org/licenses/by/4.0/).
Share and Cite
Bui, H.L.; Huang, C.-J. Tough Polyelectrolyte Hydrogels with Antimicrobial Property via Incorporation of Natural Multivalent Phytic Acid. Polymers 2019, 11, 1721. https://doi.org/10.3390/polym11101721
Bui HL, Huang C-J. Tough Polyelectrolyte Hydrogels with Antimicrobial Property via Incorporation of Natural Multivalent Phytic Acid. Polymers. 2019; 11(10):1721. https://doi.org/10.3390/polym11101721
Chicago/Turabian StyleBui, Hoang Linh, and Chun-Jen Huang. 2019. "Tough Polyelectrolyte Hydrogels with Antimicrobial Property via Incorporation of Natural Multivalent Phytic Acid" Polymers 11, no. 10: 1721. https://doi.org/10.3390/polym11101721
APA StyleBui, H. L., & Huang, C.-J. (2019). Tough Polyelectrolyte Hydrogels with Antimicrobial Property via Incorporation of Natural Multivalent Phytic Acid. Polymers, 11(10), 1721. https://doi.org/10.3390/polym11101721
